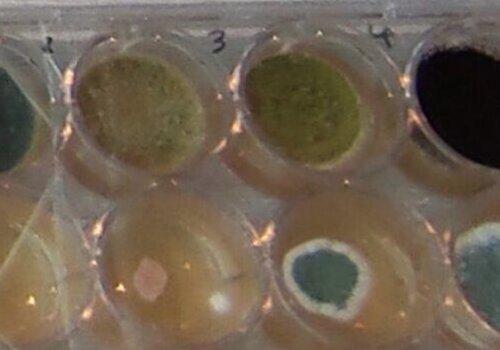

Les champignons filamenteux, saurez-vous les reconnaitre ?
Biodiversité : les champignons filamenteux, les observer et les comprendre
Thématique(s)
- Sciences de l'environnement
- Sciences de la vie et de la santé
Avec
- Nicolas Fournier > doctorant
Les champignons filamenteux, vous en voyez souvent dans votre cuisine, sur les fruits et les légumes...
Ils sont essentiels à la biodiversité, et ils ont également permis l'identification de nouveaux médicaments, dont la pénicilline.
Saurez-vous les reconnaître ?
Et leurs filaments, sous le microscope à quoi ça ressemble?
Voici différents points que vous pourrez élucider grâce à cet atelier.
Informations pratiques
Publics concernés
3 - 6 ans, 6 - 11 ans, 11 - 15 ans, 15 - 18 ans, 18 - 25 ans, 25 ans et +